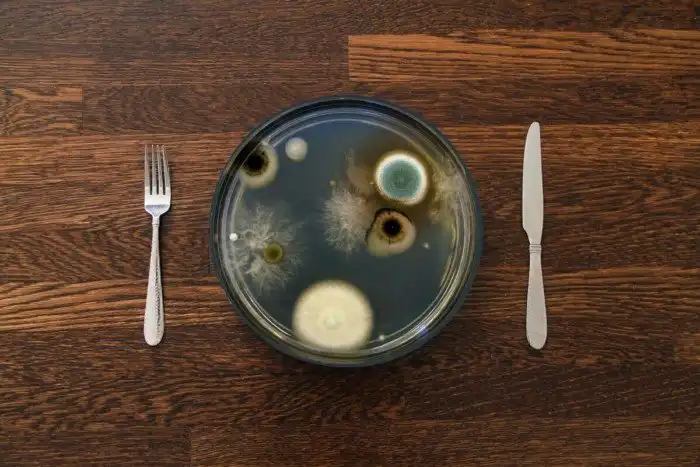

«Если он, осмотрев язву, увидит, что язва на стенах дома состоит из зеленоватых или красноватых ямин, которые окажутся углубленными в стене, То священник выйдет из дома к дверям дома и запрет дом на семь дней. В седьмой день опять придет священник, и если увидит, что язва распространилась по стенам дома, То священник прикажет выломать камни, на которых язва, и бросить их вне города на место нечистое, А дом внутри пусть весь оскоблят, и обмазку, которую отскоблят, высыпят вне города на место нечистое.»
Ветхий Завет, книга Левит: 14-37, Строки про борьбу с плесенью, минимум 2,5 тысячелетней давности.
Ротшильдская Тора, Германия 13-ый век (содержит все 5 книг, включая Левит):
Вообще, если отсчитать сухой костлявой рукой ваши оптимистичные 90 песчинок предполагаемой жизни, взвешивая их в ладони, разглядывая и изучая, как это много и мало одновременно, то представьте, что будет, если высыпать на них ещё ведро с песком истории человеческого вида вплоть до самых первых гоминидов самой зверской наружности, а потом ещё 1 кубометр того же самого песка, но весом в полторы тонны, в котором приблизительно 2 млрд песчинок. Это и будет возраст первых окаменелостей с признаками грибов. И вас вместе с историей вашего вида эта груда лет засыплет по самую макушку. Отдельной группой на полянке классификации стоят плесневые грибы. Они - незаменимая составляющая нашей жизни, жизни всей планеты, и самая их значимая роль в нашей смерти. Если бы из всех существ, животных, грибов, бактерий и вирусов нужно было бы выбрать один, который соответствовал бы слову Тлен, пожалуй, победила бы именно плесень. Именно её мы видим в заброшенных домах Припяти, она поглощает пищу, к которой уже никто не притронется, ею обрастают старые погреба, сырые доски и вещи, брошенные на свалку, сырые обои и гипсокартон в вашем туалете. Добро пожаловать в пост «Домашний тлен: токсины черной плесени».
Две стороны одной зелененькой монеты
Будь то Александр Флеминг с его невероятным галстуком-бабочкой и голубыми глазами, сделавший два важнейших для человечества открытия за счет собственной небрежности и разгильдяйства: сначала чихнув в чашку Петри с бактериями, занеся в лабораторный материал сопли и открыв таким образом лизоцим в 1922, а затем, допустив попадание пыли и спор в культуру стафилококка, который он изучал, вырастил Penicillium rubens в 1929, нечаянно открыв свойства пенициллина. Или будь то Госпитальное братство святого Антония, лечившее в средние века гангренозные поражения из-за отравлений склероциями (формой зимовки спорыньи вида Claviceps purpurea) - эрготизм или “огонь святого Антония”. В одном случае плесень спасла миллионы жизней от мучительной смерти из-за гангрены, сепсиса и заражений, в другом сама вызывала эпидемии с десятками тысяч жертв, медленно гниющих заживо с теми же гангренами и сепсисами, сходящих сума от токсинов, на основе которых позже, кстати, сделали ЛСД.
Слева - Александр Флеминг, справа - последствия поедания спорыньи, картина Матиуса Грюнвальда.
Эволюционная ирония кроется в абсолютной неоднозначности плесени. В какое бы пушистое и склизкое место её таксономии мы бы не ткнули любопытным пальцем ученого, везде есть миллион маленьких “но”. Практически всегда на сколько она опасна, ровно на столько же и нужна. Но что мы знаем точно, так это то, что пушистые грибы любого вида в состоянии доставить вам проблем.
В разгар Французской революции 1789 года молодой статный 22-летний солдат начинает жаловаться на сильнейшую лицевую боль в области скулы. Первичный осмотр показал целостность зубов, и откосить парню не дали. Затем к лицевой боли добавился экзофтальм: правый глаз внезапно вылез из орбиты. Его немедленно направили в госпиталь. Попав в отделение полевой хирургии тех лет, Жак Тибо начал побаиваться за свою жизнь. Назначили операцию. Ему перфорировали альвеолярный отросток. По результатам операции в верхнечелюстной пазухе обнаружили грибковую пористую массу. Доктор начисто отказался её вырезать из-за сильного кровотечения и невозможности продолжать операцию ввиду её сложности. Парня зашили вместе с грибом обратно и отправили, откуда пришел.
Пособие по глазным операциям и набор инструментов 18-го века:
Через 22 дня странная опухоль ещё чуть-чуть подросла, заполнив часть его рта и всю правую ноздрю, начав вызывать трудности с глотанием и дыханием. Его повторно направляют в госпиталь уже в Париже, где хирурги всё-таки удаляют и вычищают мицелий. Для предотвращения дальнейшего разрастания применяют белое прижигание.
Тогда его было три вида: черное, красное и белое. Рассказываю, чтобы вы понимали суть всего медицинского процесса. Названия даны по цветам накала металлического инструмента. Черным прижигали хронические болезни костей, суставов, лечили нервы (истерические состояния). Красненьким по инструкции несильные кровотечения из кости или лунку после удаления зуба. Ярко-красным для лечения свищей, язв и гнойных ран. Жаку назначили белое прижигание (им, кстати, лечили и простатит, вводя раскаленную добела иглу в простату). Прижигание грибка Жаку помогло на какое-то время. Но спустя пару недель на задней части неба опять появились новообразования. Их прижгли тем же способом, понаблюдали за больным и, так как из него больше ничего не вырастало, спустя 134 дня выписали. Дальнейшая судьба французского солдата и его внешний вид после операций неизвестны. Но де факто он был первым зарегистрированным пациентом с жутковатой проблемой, вызванной тем, что его пытались съесть заживо грибы рода Aspergillus вида fumigatus.
Ещё за сто лет до этих событий в далеком 1729 году итальянский священник и биолог Пьер Антонио Микели при каталогизации плесени заметил их любопытное сходство с аспергиллом (Aspergillum, с латыни spargere - распрыскивать) или, по-русски, с церковным кропилом. А затем в 1863 году француз Георг В. Фрезениус, занимаясь исследованиями легочных поражений, разделил аспергилловый род плесеней на виды, выделив из него fumigatus (от лат. fumeus - дымчатый). Такое вот дымчатое кропило. Фумигатус невероятно широко распространен в природе, его споры размером всего 2-3 мкм разносятся с каждым дыханием свежего ветра в каждую минуту существования жизни на земле вот уже многие миллионы лет.
Церковное кропило и одноименная плесень:
По своему призванию он сапротроф, как и большинство других представителей плесени (saprós - «гнилой» и trophē - «питание»), и профессионально разваливает сложные биологические соединения клеток на простые, возвращая всяческую органическую мертвечину в лоно матушки-природы. Больше всего его можно найти в компосте, где идет активный процесс гниения органики. Грибок умеет формировать два типа колоний: пушистые и бархатистые. Весьма живуч и выживает вплоть до 70 градусов Цельсия. Каждый день мы вдыхаем сотни его спор. Но наша иммунная система справляется и успешно нейтрализует попавшие грибковые патогены. Тогда почему заболел Жак?
Опухоль в сердце туманного альбиона
В 2016 году одна жительница Британии, практически из её географического центра - Ноттингема опубликовала историю мучений, постигших её в последние годы жизни. Статья вышла под названием «Когда я умирала». Перескажу кратко и по возможности точно:
“В течение многих лет я страдала от приступов болезни и множества симптомов, напоминающих непрерывный грипп. Я не могла остановить кашель, потела по ночам, испытывала физическое истощение. Меня постоянно лечили антибиотиками и антигистаминными препаратами. Ранее у меня диагностировали астму, и я каждое утро выкашливала коричневые пробки слизи.
Последний приступ болезни произошел в марте 2015 года, по интенсивности он был очень похож на предыдущий, с постоянной болью в правом легком. Курс антибиотиков ничего не дал, выписали сальбутамол и отправили на рентген. Рентген показал образование в правом легком. Отправили на КТ. Кашель усиливался. Приступы переходили в рвоту. Дышать было невозможно даже с сальбутамолом. По результатам КТ доктора поставили диагноз «сильно разросшаяся злокачественная опухоль, частичная обструкция легкого». Отправили на бронхоскопию, которую сделать не удалось из-за проблем с дыханием”.
Рентгенограмма небольшой грибковой опухоли:
Женщина начинает готовиться к своим похоронам и искать место для операции, обзванивая платные раковые центры. Её навещают родные, близкие и друзья. Её поддерживают, и это здорово. Ей становится хуже с каждым днем. Хотя ничего, кроме КТ и рентгена, на рак не указывает. Её переводят в разные учреждения, пока медицинская комиссия вместе с врачом-диагностом не ставит под подозрение диагноз, основанный только на снимках. Посовещавшись в медицинских кругах, они начинают подозревать, что это может быть и не рак. Назначают новые анализы. В их числе анализ имунноглобулина Е к аспергиллезу. Полученный результат оказался настолько высоким, что был вне оценочной шкалы. У женщины обнаружили запущенный и разросшийся аллергический бронхолегочный аспергиллёз. Картина была настолько жуткой, что и КТ, и рентген в точности совпадали с характеристиками и внешним видом злокачественной опухоли, занимавшей почти всё легкое.
Рентгенограмма большой грибковой опухоли:
Бэтси в итоге спасли, и она успешно перешла от острой формы к хронической, оставшись на этом свете с кашлем, необходимостью постоянного лечения и жутковатым жизненным опытом. В её случае врачи пришли к мнению, что виновником заболевания стала компостная куча на заднем дворе, где у Бэтси был сад. Но так ли всё просто?
“Аспергиллез” лишь общее название весьма нескромной группы болезней, вызываемых грибами рода Aspergillus. В большинстве своем, заболевание наиболее характерно для уже больных или сильно ослабленных людей. Это все, кто перенес или всё ещё болеет самыми разными болезнями, связанными с легкими: от туберкулеза и хронической обструктивной болезни легких до астмы и тяжелых форм аллергий. В случае с Бэтси она обзавелась аспергилломой, проще говоря, в её легких разросся грибной мицелий. Чтобы в бронхе или в легком выросли грибы, недостаточно просто вдохнуть споры плесени. Вы и так это делаете постоянно. Для того, чтобы они прижились, необходимо иметь повреждения (в виде гранулемы, например). И тогда, попав в полость гранулемы, абсцесса или кисты, споры прорастают, и начинает расти аспергиллома.
Процесс может быть очень долгим, ткани бронхов и легких будут постепенно разрушаться, вовлекаясь в формирование детрит - мертвых клеток в основе гриба. Больной может долгое время просто покашливать, пока его состояние постепенно деградирует, приступы становятся сильней, появляется слизь и мокрота, она становится зеленоватой, присоединяются хлопья, кровь, куски бронхов и гриба. Сама по себе аспергиллома может вырасти практически где угодно, но на первом месте легкие из-за наибольшего количества спор, попадающих туда, на втором ушной канал. Но если споры попали в лишенный защиты организм, унести их может и в печень, и в почки. Где при низком или нарушенном иммунитете - обязательно что нибудь вырастет. Жаку вот не повезло с верхнечелюстной пазухой.
Макрофотография небольшой аспергилломы в тканях:
Раньше вырастить в себе гриб было относительно сложно. Лабораторные наблюдения в крупных городах типа Сан-Франциско выявляли 1-2 случая на 100 000 населения (данные за 1992-1993 годы). Но с тех пор, как появились иммунодепрессанты, которыми стали лечить разные виды аллергий, и участились имплантации органов, только в США стали регистрировать больше 15 000 случаев в год инвазивных форм аспергиллеза. Если вам этого мало - добавьте сюда ещё 6 млн. человек с аллергической бронхолегочной формой. Это когда иммунная система наоборот слишком активно реагирует на споры. Появляется кашель, повреждения, рубцы...
Смертельное разнообразие.
Допустим, компостной кучи у вас ни в офисе, ни на даче, ни на балконе нет. Туберкулезом вы не болели и печень у вас пока своя, а свежая флюорография висит на видном месте - где-то на холодильнике. Перенесемся на территорию современной Украины в начало 1920-х годов. В это время здесь произошла эпидемия, унесшая жизни нескольких тысяч лошадей. В качестве симптомов у лошадков описывали появление корочек и шелушения на губах, раздражение слизистых носа, горла и рта, трудности с глотанием, кровотечения, поражения нервной системы и смерть. Время было тяжелое, причины установить не удалось. Эпидемия загадочно началась и так же загадочно закончилась.
Фотография первых признаков поражения у животных, начало 20-го века:
С 1930-х годов начинают регистрироваться случаи схожих эпидемий и среди людей, но совсем другого масштаба и жути. Первые очаги возникают на Урале и в Западной Сибири. Так, во время войны произошла вспышка заболевания получившего название «септическая ангина» или научно - алейкия алиментарно токсическая. Характерными симптомами стали снижение лейкоцитов в крови, высокая температура, некрозы в полости рта и глотке, кровоизлияния на коже. Смертность местами превышала 50%. Свидетели заболевания описывали апокалиптичные картины с обильными кровотечениями, когда больные десятками лежали в пропитанных кровью кроватях и от них шел сладковатый запах гнили. Пик заболеваемости пришелся на 1944 год, унося десятки тысяч жизней в, и без того опустошенной, стране. Спустя несколько лет, наконец удалось идентифицировать причины. Ими оказались два рода плесени: Stachybotrys - в случае с лошадьми, и Fusarium - в случае с ангиной. А ещё через 10 лет ученые открыли для себя мир микотоксинов и, как говорится, - понеслось.
Fusarium, в переводе с латыни - “веретено”. И, если Fusarium sporotrichoides, которым были поражены запасы зерна в СССР, вызвало десятки тысяч жутких смертей, то,например, Fusarium venenatum производят промышленно для использования в пищу потому, что он богат белком. Из него делают то самое искусственное мясо. Еще 3-4 вида могут вызывать инфекции в ногтях и роговице глаза. Поедание зерна, пораженного sporotrichoides, опасно впервую очередь трихотеценовыми микотоксинами, которые вырабатывает плесень, а не самой плесенью, как таковой. Для “фузариумов с.” это знаменитый микотоксин Т2, который после открытия постоянно пытаются приписать кому-нибудь (нам) в контексте применения биологического оружия, это и Желтый дождь (не путать с золотым) в Лаосе и Афганистане (1975-1981), и поставки в Ирак, и «Буря в пустыне».
Если посмотреть на микотоксин Т2 пристальней, то механизм воздействия покажется весьма и весьма интересным. Соединение с формулой С24Н34О9, попав с пищей в организм, проникает в клетки и перегружает их окислительным стрессом. Проще говоря, образуется слишком много молекул с непарными электронами (свободные радикалы), и они “тырят” эти электроны из того, что есть рядом, разваливая всё, вплоть до ДНК. После чего клетка или сама решает, что ей конец и запускает самоуничтожение (апоптоз), или некротирует (умирает) из-за повреждений. В обоих случаях вам тоже “жопа”. Отсюда и симптомы. В США были такие же вспышки, но с Fusarium Culmorum. Это плесень, которая больше любит кукурузу и производит вомитоксин, от англ. - “блевать”. При употреблении ваш главный симптом - безудержная и неукротимая рвота. Это лучше, чем некроз, но всё равно не очень. Большинство Фузариумов помогают растениям и живут с ними в симбиозе, они селятся в почве возле корней и помогают им питаться, переживать засуху. Но в случае с урожаем, они просто меняют место жительства с корней на плоды и, из-за нарушений условия хранения, прорастают, отравляя пищу.
Советская лаборатория:
Stachybotrys chartarum - та самая черная плесень на обоях, бумаге или книгах. В природе она разлагает целлюлозу в отсутствии прямых солнечных лучей и высокой влажности. Впервые её задокументировал, как проблему в сфере ЖКХ, аж в 1837 году в одном из домов Праги чешский миколог Карл Джозеф Корда. Стахиботрис не исключение в роду токсичных грибов - вырабатываемый ею Сатратоксин-Н, хоть и не числится химическим оружием, является крайне опасным для жизнедеятельности таких макроорганизмов, как мы с вами. Он абсолютно универсален в отношении проникновения внутрь нашей тушки: можно вдохнуть, можно съесть, можно потрогать и пощупать - вам в равной степени станет плохо. В зависимости от места соприкосновения, можно заполучить: сыпь, боли в груди/грудях, головную боль, чувство усталости, кровотечение в легких, кашель.
Вездесущие патогены.
В принципе, скажете вы, ничего сложного. Надо всего лишь следить за качеством сельскохозяйственных продуктов и не допускать заплесневения чего бы то ни было. Но в этом и кроется величайший подвох плесени. Мы используем её везде: от сыра (Penicillium spp. и Penicillium camemberti), батончиков мюсли из соевых бобов (Rhizopus oligosporus), искусственного мяса (Fusarium venenatum), черного чая (имею ввиду пуэр), хереса (Botrytis cinerea), до соевого соуса и мисо пасты (Aspergillus oryzae), и в десятках других продуктов. И, даже если бы мы этого не делали, она всегда с нами. Её споры в воздухе, на земле и в воде. Неизменно. Миллиарды. Лет. Но что же изменилось, спросите вы?
Чаша Петри с плесенью. Названа так в честь немецкого бактериолога Юлиуса Рихарда Петри, ассистента Роберта Коха.
Например, промышленная революция родила одно из своих детищ - массовое строительство жилья. Первый завод по производству гипсокартона открылся в Рочестере, штат Кент, в Великобритании в 1888 году, но по-настоящему штампованные панели заняли рынок после Второй Мировой Войны во время строительного бума. Сейчас странные стены из бумаги и гипсовой штукатурки есть в каждом доме. В каждой квартире. И это самый яркий пример, заметьте. Все дело в том, что в пористой гипсовой структуре, насыщенной влагой, на волокнах целлюлозы прорасти может не только Stachybotrys, а практически любой вид плесени. Сам гипсокартон зачастую изготавливают с нарушениями норм. США, например, после урагана Катрина к Китаю, поставившему гипсокартон для многих строительных фирм, выставили многомиллионные иски за нарушение стандартов и наличие токсичных соединений, обнаруженных при исследовании последствий бедствия.
В ноябре 1994 года доктор Дорр Дирборн из детской больницы в восточной части Кливленда, Огайо, США, после одного затяжного ливня столкнулся со вспышкой одного из редких до этого времени заболеваний. В один и тот же день к нему поступило трое новорожденных детей с кровотечением в легких. Когда на завтра дети продолжили поступать, он забил тревогу и вызвал федеральных представителей службы здравоохранения. На заболевание обратили пристальное внимание. Спустя пару месяцев, расследование привело к черной плесени. Необычный ливень подтопил несколько районов города и вызвал повреждения в старых домах. Всё вместе это привело к высвобождению спор, спровоцировавших кровотечение и проблемы с легкими у новорожденных. Их иммунитет не справился.
Одной из последних капель в вопросе заселения плесени в наши дома стал топливный кризис 70-х, после которого мы стали экономить энергоресурсы, утеплять дома, герметизируя их, постепенно доводя это искусство до совершенства. Мы стали изменять саму среду вокруг нас, расплачиваясь за комфорт здоровьем. Плесень может жить и живёт на побелке, обоях, бумагах, книгах, тканях, одежде, коврах, древесине и досках. Любой органический материал, начиная с мертвого фикуса у вас на балконе и заканчивая пылью в сетке кондиционера - благодатный субстрат для роста грибов. Мы изменили даже городские почвы и воздух. Изменился баланс спор в естественной природе и в мегаполисах - разные уровни разных видов спор. Если в зональной почве это Пенициллы, то на вашем засранном газоне возле подъезда это Аспергиллы.
Борьба бесконечности.
Чем только её, бедную, не выводят из дома. На первом месте, наверное, все виды отбеливателей, белизнителей и разных брендов, продающих хлорную известь - коррозивно-активное вещество второго класса опасности в комбинации с разными отдушками и чудо-компонентами, которые в кривых руках собранные вместе вызывают симптомы, успешно конкурирующие с хроническим аспергиллезом. Мало кто вдается в подробности унитазной химии, добавляя всё подряд поверх всего подряд. Но, например, смешивание гипохлорита кальция с сильной кислотой возвращает хлор в его первоначальное состояние, после чего останется только глубоко вдохнуть, чтобы получить проблемы с лёгкими. На втором месте, наверное, вездесущий пероксид водорода. Он относится к кислороду в активной форме, проще говоря, действует по тому же принципу, что и токсин Т2, вызывая окислительные процессы, хотя и не так активно. Проблема в том, что, чтобы процессы были активней, концентрация должна быть выше. 3%-ный пероксид отлично растворяет ушные пробки, размягчает и помогает промывать некротизированные участки тканей, сгустки крови и гноя. Но чтобы удалить плесень, придётся взять его концентрированную версию, которая как раз опасна не меньше самого токсина.
Применение хлора немцами в годы первой мировой войны:
Почему-то, когда дело касается нашего организма или еды, мы не занимаемся самолечением, возвращаясь в 18 век и прижигая молочницу на слизистых, калёным железом клеймя свои интимные прелести, и не травим хлоридом ртути грибок на ногтях. Семена растений стерилизуют фунгицидами, а не замачивают их в пероксиде. Но как дело доходит до бытовой химии, мы в лучшем случае пользуемся методами Ветхого завета, хотя человечество уже давно изобрело вполне себе действенные лекарства и для бытовых нужд. Соединения на основе формалина и токсичной серы сменили средства, подобранные индивидуально под домашние пушистые застенки.
Не так давно в моде были биологические фунгициды на основе спор Ampelomyces quisqualis, и это - плесень паразит плесени. Попав в нужное место, она расползается по мицелию, куда бы он не шёл, до тех пор пока не сожрет его полностью. Её споры не так токсичны, как у патогенных штаммов, но и она не идеальна.
Пример гиперпаразитизма на примере Ampelomyces quisqualis, поедающего собрата побольше:
Отдельно эволюционировали безопасные соединения катионных полиэлектролитов, таких как полиэтиленимин, способный формировать макромолекулы и проникать в целлюлозу, занося вглубь структуры, пожираемой мицелием, нужные фунгициды. Это всё настоящие химики смешивают за вас со сложным набором поликарбоновых кислот и повсеместно изготавливают и продают под самыми разными брендами, вроде того же Септоцила.
Пока вы играете в домашних химиков, пытаясь оттереть уксусом организм, который 2 млрд. лет приспосабливался к обитанию на каменистой поверхности или поглощению целлюлозы, затыкаете вентиляционные отверстия, стараясь максимально утеплиться и сделать свою среду самой комфортной на свете, нужно иметь в виду, что эта среда понравится не только вам.
Даже самая крохотная чёрная точка на любой из поверхностей - это объявление войны, в которой вы будете участвовать, хотите того или нет.